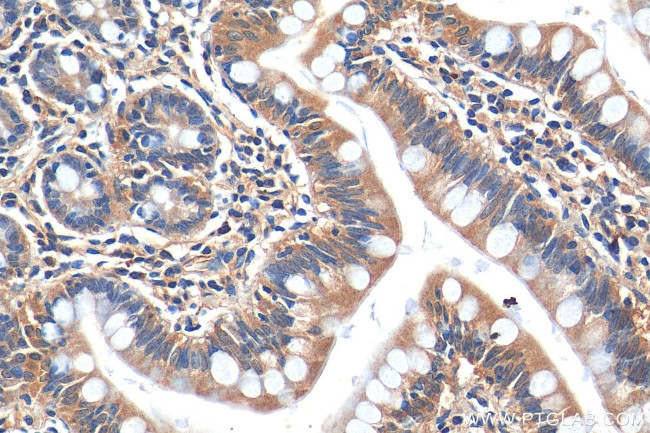
HTR3A Antibody in Immunohistochemistry (Paraffin) (IHC (P))

Search
Proteintech
HTR3A Polyclonal Antibody
{{$productOrderCtrl.translations['antibody.pdp.commerceCard.promotion.promotions']}}
{{$productOrderCtrl.translations['antibody.pdp.commerceCard.promotion.viewpromo']}}
{{$productOrderCtrl.translations['antibody.pdp.commerceCard.promotion.promocode']}}: {{promo.promoCode}} {{promo.promoTitle}} {{promo.promoDescription}}. {{$productOrderCtrl.translations['antibody.pdp.commerceCard.promotion.learnmore']}}
产品信息
29685-1-AP150UL
种属反应
宿主/亚型
分类
类型
偶联物
形式
浓度
规格
纯化类型
保存液
内含物
保存条件
运输条件
靶标信息
The product of this gene belongs to the ligand-gated ion channel receptor superfamily. This gene encodes subunit A of the type 3 receptor for 5-hydroxytryptamine, a biogenic hormone that functions as a neurotransmitter, a hormone, and a mitogen. This receptor causes fast, depolarizing responses in neurons after activation. It appears that the heteromeric combination of A and B subunits is necessary to provide the full functional features of this receptor, since either subunit alone results in receptors with very low conductance and response amplitude. Alternatively spliced transcript variants encoding different isoforms have been identified.
仅用于科研。不用于诊断过程。未经明确授权不得转售。
篇参考文献 (0)
生物信息学
蛋白别名: 5-HT-3; 5-HT3-A; 5-HT3A; 5-HT3R; 5-HT3R-As; 5-hydroxytryptamine (serotonin) receptor 3A, ionotropic; 5-hydroxytryptamine receptor 3; 5-hydroxytryptamine receptor 3A; 5HT3 serotonin receptor; serotonin receptor; Serotonin receptor 3A; Serotonin-gated ion channel receptor; truncated receptor; unnamed protein product
基因别名: 5-HT-3; 5-HT3; 5-HT3A; 5-HT3R; 5ht3; 5HT3R; HTR3; HTR3A
UniProt ID: (Human) P46098, (Mouse) P23979
Entrez Gene ID: (Human) 3359, (Mouse) 15561